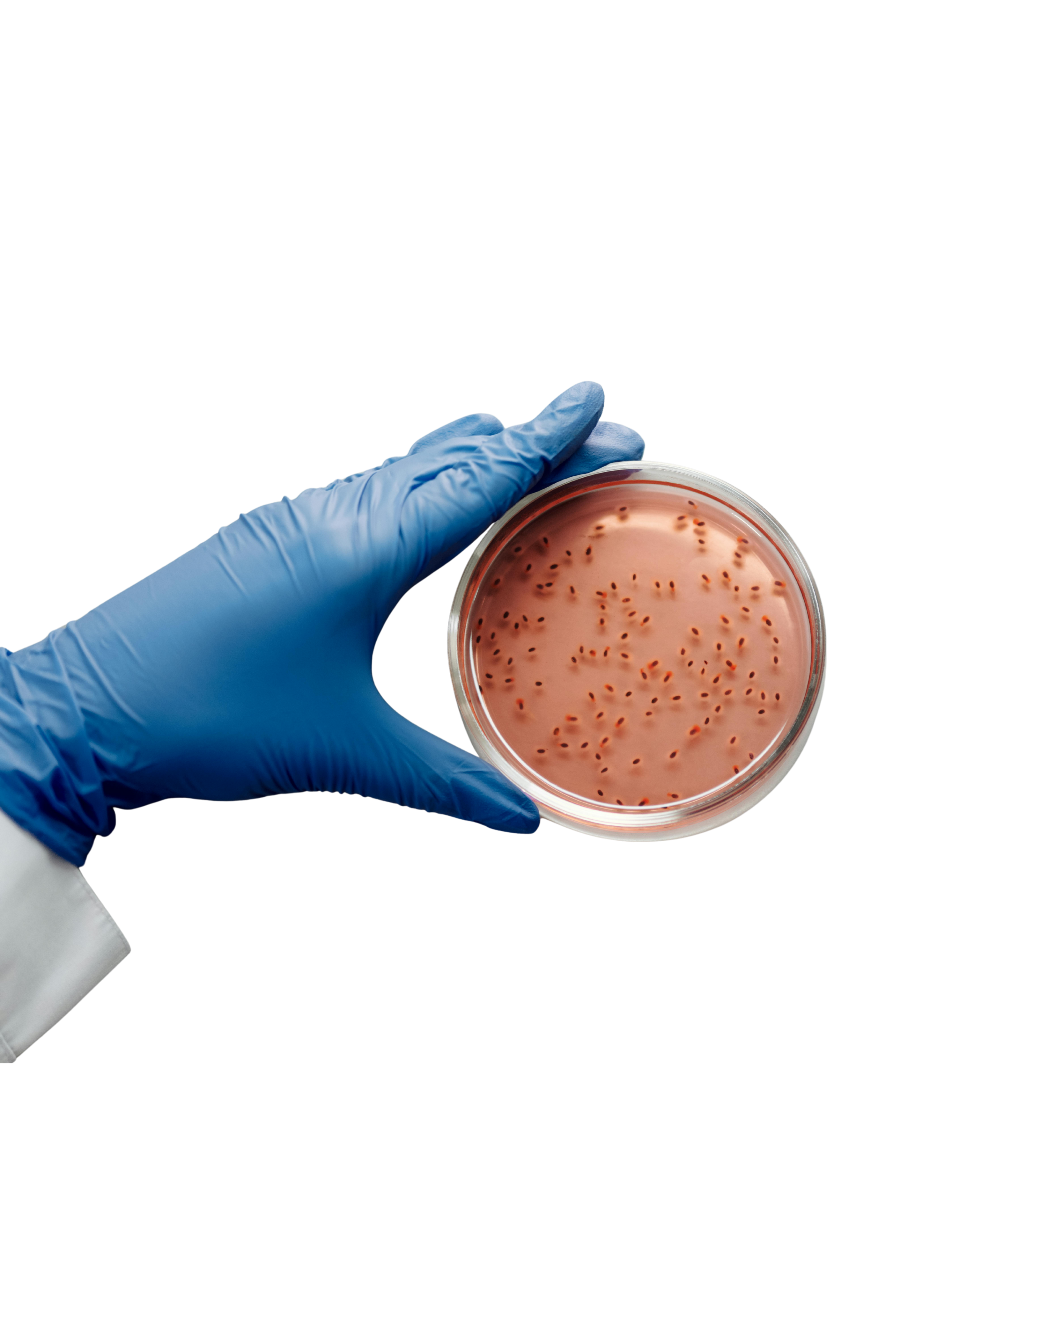

Diagnóstico Molecular como Ferramenta Decisiva na Sanidade Avícola
|
Em sistemas de produção intensiva, surtos de enfermidades infecciosas podem ocorrer e se espalhar rapidamente, comprometendo o desempenho, a segurança sanitária e os resultados econômicos da granja. Nessas situações, a rapidez no diagnóstico é essencial para identificar e conter o avanço das enfermidades. O diagnóstico molecular, especialmente por PCR em tempo real (qPCR), tem se consolidado como uma solução eficaz, permitindo a detecção precisa do agente infeccioso mesmo em estágios iniciais ou após intervenções terapêuticas. |
|||||||||||||||||||||||
|
1. Limitações dos métodos convencionais Apesar de sua importância histórica, o isolamento microbiano pode apresentar limitações devido à dificuldade de isolar, custo elevado ao pré-tratamento com antibióticos. É comum, em aves tratadas, haver alterações dos órgãos e resultados negativos em exames microbiológicos tradicionais, o que dificulta o diagnóstico e controle da infecção no plantel.
|
 |
||||||||||||||||||||||
|
2. O diferencial do diagnóstico molecular · Alta sensibilidade e alta especificidade; · Detecção do agente patogênico independente da viabilidade; · Maior precisão mesmo em amostras degradadas; · Pode detectar baixa carga microbiana ou se o animal estiver medicado; Resultados mais rápidos (menos de 24 h). |
|||||||||||||||||||||||
|
3. Benefícios do resultado rápido A rapidez na obtenção dos resultados permite a implementação imediata de medidas de contenção tais como: reforço na biosseguridade, segregação de lotes, revisão de protocolos vacinais, tratamentos e monitoramento de plantéis potencialmente expostos. |
||||||||||||||||||||||
|
4. Conclusão O diagnóstico molecular representa um avanço na sanidade avícola, unindo rapidez, sensibilidade e especificidade. Sua adoção traz mais segurança às decisões e fortalece a eficiência e sustentabilidade da produção. Veja abaixo quadro comparativo entre algumas características dos métodos moleculares com microbiologia convencional. |
|||||||||||||||||||||||
|
|||||||||||||||||||||||
|
* Multiplexação: técnica que permite a detecção simultânea de múltiplos alvos genéticos (ex: diferentes microrganismos) em uma única reação de qPCR. *Subespeciação: capacidade do método de subdividir os patógenos em grupos com pequenas, mas significativas variações *Sensibilidade: capacidade do método de detectar pequenas quantidades de material genético. *Especificidade: habilidade do teste em identificar corretamente apenas o microrganismo-alvo, evitando reações cruzadas com outros organismos semelhantes. Setor de Biologia Molecular – MercoLab Laboratórios
|
|||||||||||||||||||||||